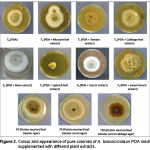
Figure 2. Colour and appearance of pure colonies of A. brassicicola on PDA media supplemented with different plant extracts.
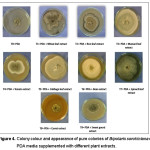
Figure 4. Colony colour and appearance of pure colonies of Bipolaris sorokiniana on PDA media supplemented with different plant extracts.

Introduction
The growth of microorganisms in an artificial medium is influenced by several physical and chemical factors. A nutrient material prepared for the growth of microorganisms in a laboratory is called culture medium and the nutrient composition of a culture medium plays a major role in microbial growth (Toratora et al.).27 In laboratory, fungi are isolated on specific and non-specific culture medium for cultivation, preservation, microscopic examination as well as biochemical and physiological characterization (Northolt and Bullerman; Kuhn and Ghannoum; Kumara and Rawal,)16,13 & 12 The most common growth media for bacteria are nutrient broths and for fungi are agar plates; specialized media are sometimes required for microorganism and cell culture growth (Madigan and Martinko).14
In this study, two pathogens were used, Alternaria brassicicola and Bipolaris sorokiniana. Alternaria species are known as major plant pathogen. There are 299 species in the genus (Kirk et al.),10 they are ubiquitous in the environment and are a natural part of fungal floral almost everywhere. The spores are airborne and found in the soil and water, as well as indoors and on objects. The club-shaped spores are single or form long chains. They can grow thick colonies which are usually green, black, or gray (Nowicki and Marcin).17Alternaria attacks a wide range of host plants such as cole crops, crucifers, brassica etc. Alternaria cause black-spotting of crucifers: Alternaria brassicae and Alternaria brassicicola. Conidia of Alternaria brassicicola are similar in length as Alternaria japonica, but have fewer longitudinal septa, are not constricted at the transverse septa, and are produced in longer chains (Tewari and Buchwaldt).26Bipolaris is a genus of fungi belonging to the family Pleosporaceae. It was circumscribed by mycologist Robert A. Shoemaker in 1959.19 Bipolaris is a large genus of dematiaceous hyphomycetes with more than 100 species, most of them being saprobes in soil and pathogens of plants, while some of the saprobic species are potentially able to infect humans and animals (Sivanesan).23 The typical morphological features of Bipolaris species include rapidly growing dark colonies, geniculate conidiophores with sympodial conidiogenesis, and large conidia with transverse distosepta, usually without a protuberant hilum (a basal structure scar indicating the point of attachment in the conidiogenous cell) and with bipolar germination. Morphologically similar anamorphic genera are Drechslera, Curvularia, and Exserohilum (Sivanesan).23
Fungi grow on diverse habitat in nature and are cosmopolitan in distribution requiring several specific elements for growth and reproduction. A wide range of media are used for isolation of different groups of fungi that influence the vegetative growth, colony morphology, pigmentation and sporulation depending upon the composition of specific culture medium, pH, temperature, light, water availability and surrounding atmospheric gas mixture (Northolt and Bullerman).16 However, the requirements of fungal growth are generally less stringent than for the sporulation. Physical and chemical factors have a pronounced effect on diagnostic characters of fungi. Hence, it is often necessary to use several media while attempting to identify a fungus in culture since mycelial growth and sporulation on artificial media are important biological characteristics (St-Germain and Summerbell).25 The experiments were performed in the laboratory condition to find out the effect of media composition on vegetative and reproductive growth of Alternaria brassicicola and Bipolaris sorokiniana on different culture media and this is the first attempt in this regard.
Materials and Methods
The experiments were conducted in the Plant Disease Diagnostic Clinic (PDDC), Department of Plant Pathology and Seed Pathology Centre (SPC), Bangladesh Agricultural University, Mymensigh-2202. The experiments were performed during the period from November 2015 to December, 2016.
Collection, Isolation and identification of Alternaria brassicicola and Bipolaris
sorokiniana
A. brassicicola and B. sorokiniana isolates were isolated from infected mustard and wheat seeds, respectively collected from farmer’s own stored seeds. After collection of infected seeds, A. brassicicola and B. sorokiniana were isolated through Standard blotter method (ISTA).9 In this blotter method, 25 (1+8+16) mustard and wheat seeds were placed respectively on moist blotter paper (wetted with sterile water) in plastic petridishes. Then the petridishes were incubated at the incubation room 25°C to provide the conditions for the pathogen to sporulate and after 7-10 days pathogenic structures (spores and mycelia) on seeds were observed under stereo binocular microscope. Then the infested seeds were maintained on Potato Dextrose Agar (PDA) medium for 7-10 days in the incubation room and ensured about the presence of concern pathogens by preparing slide and comparing the morphological characters following the key outlined by Barnett1 and Ellis6 (Figure 1). The pure culture of both fungi were obtained by culturing fungi on PDA medium and making the fresh culture from “hyphal tip” selected from the periphery of actively growing colony under aseptic conditions. After inoculation of fresh PDA plates with fungal block, the inoculated plates were sealed with parafilm and the fungal isolates were grown under optimum growth conditions (23 ± 1°C) for 10 days.
 |
Figure 1: Different structures of Alernaria brassicicola (A) and Bipolaris sorokiniana (B) |
Experimental treatments
To study the effect of media composition on vegetative and spore production of A. brassicicola and B. sorokiniana, eleven treatments were used for A. brassicicola and ten treatments for B. sorokiniana.
Treatments forAlternaria brassicicola isolate
T0= PDA (control)
T1= PDA + Mustard leaf extract
T2= PDA + Tomato fruit extract
T3= PDA + Cabbage leaf extract
T4= PDA + Bean fruit extract
T5= PDA + Spinach leaf extract
T6= PDA + Carrot fruit extract
T7= PDA + Sweet gourd fruit extract
T8= T1 (PDA + Mustard leaf extract) +Tomato fruit extract
T9= T8 (PDA + Mustard leaf extract + Tomato fruit extract) + Carrot fruit extract
T10= T9 (PDA + Mustard leaf extract + Tomato fruit extract + Carrot fruit extract)
+Cabbage leaf extract
Treatments for B. sorokiniana isolate
T0= PDA (Control)
T1= PDA + Wheat leaf extract
T2= PDA + Rice leaf extract
T3= PDA + Mustard leaf extract
T4= PDA + Tomato fruit extract
T5= PDA + Cabbage leaf extract
T6= PDA + Bean fruit extract
T7= PDA + Spinach leaf extract
T8 = PDA + Carrot fruit extract
T9 = PDA + Sweet gourd fruit extract
PDA medium/growth medium preparation
For this preparation 200g of clean peeled slice potato tubers were boiled in 500 ml of water. Water was separated from boiled potato slices. 20g Dextrose and 15g Agar was added to separated boiled water and made the final 1000 ml volume of PDA medium with distilled water. Then the medium was autoclaved at 121˚C , 15 PSI for 15 minutes and after proper cooling the medium, the PDA plates were prepared within laminar air flow cabinet.
Changing the media composition for the growth of Alternaria brassicicola
To prepare a modified PDA medium, different plant extracts were added to PDA @ given in the Table 1.
Table 1: Supplemented PDA media with their composition and name
|
Volume of medium (ml) |
PDA ingredients |
Name of plant extract |
Quantity (ml) of plant extract (1:5) |
Name of the medium |
|
250 |
Decoction of 150 ml Potato, 5g Agar, 5g Dextrose. |
Mustard leaf |
100 |
Potato mustard leaf agar (PDA+mustard leaf extract) |
|
250 |
Decoction of 150 ml Potato, 5g Agar, 5g Dextrose. |
Tomato fruit |
100 |
Potato tomato fruit agar (PDA+tomato fruit extract) |
|
250 |
Decoction of 150 ml Potato, 5g Agar, 5g Dextrose. |
Cabbage leaf |
100 |
Potato cabbage leaf agar (PDA+ Cabbage leaf extract) |
|
250 |
Decoction of 150 ml Potato, 5g Agar, 5g Dextrose. |
Bean fruit |
100 |
Potato bean fruit agar (PDA+ bean fruit extract) |
|
250 |
Decoction of 150 ml Potato, 5g Agar, 5g Dextrose. |
Spinach leaf |
100 |
Potato spinach leaf agar (PDA+ Spinach fruit extract) |
|
250 |
Decoction of 150 ml Potato, 5g Agar, 5g Dextrose. |
Carrot fruit |
100 |
Potato carrot fruit agar (PDA+ Carrot fruit extract) |
|
250 |
Decoction of 150 ml Potato, 5g Agar, 5g Dextrose. |
Sweet gourd fruit |
100 |
Potato sweet gourd fruit agar (PDA+ sweet gourd fruit extract) |
|
250 |
Decoction of 150ml Potato, 5g Agar, 5g Dextrose. |
Mustard leaf + Tomato fruit |
50+50 |
Potato, mustard leaf tomato fruit agar (PDA+Mustardleaf+Tomato fruit extract) |
|
250 |
Decoction of 150ml Potato, 5g Agar, 5g Dextrose. |
Mustard leaf+ Tomato fruit+ Carrot fruit |
33+33+34
|
Potato mustard leaf, tomato fruit, carrot agar (PDA+Mustardleaf+Tomatofruit+Carrot fruit extract) |
|
250 |
Decoction of 150ml Potato, 5g Agar, 5g Dextrose. |
Mustard leaf+ Tomato fruit+ Carrot fruit +Cabbage leaf+ |
25+25+25+25 |
Potato mustard leaf, tomato fruit, carrot fruit, cabbage leaf agar (PDA+Mustardleaf+Tomatofruit+Carrotfruit+Cabbage leaf extract) |
After cooking, the media were poured into conical flask and the mouth of the conical flask was closed with non-absorbent cotton plug and sterilized in an autoclave at 1210C under 15 PSI for 20 minutes. After autoclaving, 10-12 drops of lactic acid was added in the media for avoiding bacterial contamination and then all the media were transferred into petridishes and each of the petridishes contained 20 ml of media.
Changing the media composition for the growth of Bipolaris sorokiniana
Media composition was changed by adding different types of host and non-host plant extracts with PDA medium. Potato wheat leaf agar medium was prepared by mixing 100ml of wheat leaf extract (1:5) with boiled water extract of 150ml sliced potato, 5g agar and 5g dextrose for 250ml of medium. On the other hand, Potato rice leaf agar medium was prepared by mixing 100ml of rice leaf extract (1:5) with boiled water extract of 150ml sliced potato, 5g agar and 5g dextrose for 250ml of medium.
Moreover, the other supplemented media such as potato mustard leaf agar medium (PDA+ Mustard leaf), potato tomato agar medium (PDA+Tomato), potato carrot agar medium (PDA+Carrot), potato bean agar medium (PDA+Bean), potato spinach leaf agar medium (PDA+Spinach leaf), potato cabbage agar medium (PDA+Cabbage) and potato sweet gourd agar medium (PDA+Sweet gourd) were prepared following the procedure described above (Table 1).
Inoculation of the culture media plates with A. brassicicola and B. sorokiniana
isolates
PDA plates supplemented with different plant extracts were inoculated with pure culture of A. brassicicola and B. sorokiniana. In brief, mycelial blocks were cut out of 10 days old fungal colony near the margin by means of sterilized cork borer of 5 mm diameter. These blocks were transferred to the center of the petri plates by means of a sterilized inoculating needle. For each of the treatments three replications were maintained. All these were done under aseptic condition inside a laminar air flow cabinet which was sterilized previously by spraying 70% ethanol.
Observation of vegetative growth for both of the fungus isolates on different media
Color of colony and substrate and margin of colony were observed by naked eye for both of the fungal isolates.
Fungus growth measurement technique
In case of all supplemented media, mycelial growth for both the fungi were determined directly by measuring the diameter of the colonies in the same axis. Mycelial growth of the colony was measured with the help of fine transparent plastic scale in cm and the sporulation for the both fungi were determined by spore counting using hemocytometer in spores/ml.
Measurement of vegetative growth rate
After 10 days, mycelial growth of A. brassicicola and B. sorokiniana colony were recorded by measuring the average of two diameters at right angles to one another. The same procedures were repeated three times and mean number of mycelial growth was considered.
Measuring sporulation
The degree of sporulation for both fungi were determined by adding 5 ml of double distilled water and 2.5 ml of 70% ethanol in each petridish containing 10 days old pure culture of those fungi. Then the surface of the fungal growth on PDA was scraped gently with a camel hair brush to disperse the spores. After that 3 ml of the suspension and 22 ml double distilled water were taken in a falcon tube and then shaken until it mixed well. From the final suspension 100 µl was placed in a hemocytometer and the number of conidia were counted under compound microscope and number of conidia/ml was estimated by using the key outlined by Tuite.28 The same procedures were repeated three times for three replications and mean number of conidia/ml was determined.

Statistical analysis
The experiments were done under controlled laboratory condition, and the data were analyzed following completely randomized design (CRD) by using the SPSS statistical software.
Results
This research work was conducted to select the best media composition suitable for the vegetative and reproductive growth of Alternaria brassicicola and Bipolaris sorokiniana. The tested fungal isolates were grown in PDA media supplemented with different plant extracts. The results of the experiments are given below-
Growth characteristics of Alternaria brassicicola on PDA media supplemented with different plant extracts
The growth characteristics like colour of substrate/media, color of colony and margin of colony of Alternaria brassicicola on different culture media were observed in this study. The colony colour of A. brassicicola having dark brown centre and white margin in case of PDA media and PDA supplemented with mustard leaf extract and cabbage leaf extract. Whereas, PDA media supplemented with tomato fruit, bean fruit, carrot fruit, spinach leaf and sweet gourd fruit showed light brown, light brown centre and white margin, whitish, brown centre and white margin and brownish colony respectively (Table 2; Figure 2). This result indicating that PDA media supplemented with different plant extracts have an impact on the colony color of A. brassicicola. On the other hand, margin of the pure colony of A. brassicicola on PDA medium and PDA supplemented with different plant extracts showed mostly regular form. On sweet gourd and spinach leaf extract supplemented medium, the colony appeared irregular (Table 2; Figure 2).
Table 2: Colony characters of Alternaria brassicicola on PDA media supplemented with different plant extracts
|
Treatments |
Colony characters |
||
|
Substrate color /Media color |
Colony color |
Margin of colony |
|
| T0= Potato dextrose agar |
Light brownish |
Dark brown centre and white margin |
Regular |
| T1= Potato mustard leaf agar |
Green |
Dark brown centre and white margin |
Regular |
| T2= Potato tomato fruit agar |
Reddish |
Light brown |
Regular |
| T3= Potato cabbage leaf agar |
Light green |
Dark brown centre and white margin |
Regular |
| T4=Potato bean fruit agar |
Light green
|
Light brown centre and white margin |
Regular |
| T5= Potato spinach leaf agar |
Dark green |
Whitish |
Irregular |
| T6= Potato carrot fruit agar |
Red
|
Brown centre and white margin |
Regular |
| T7= Potato sweet gourd fruitagar |
Brown |
Brownish |
Irregular |
| T8= Potato mustard leaf,tomato fruit agar |
Light brown |
Dark black to brown |
Regular |
| T9= Potato mustard leaf,tomato fruit, carrot fruitagar |
Light brown |
Dark black to brown along with whitish margin |
Regular |
| T10= Potato mustard leaf,tomato fruit, carrot fruit,cabbage leaf agar |
Light brown |
Greenish |
Regular |
|
Figure 2: Colour and appearance of pure colonies of A. brassicicola on PDA media supplemented with different plant extracts. Click here to View figure |
Effect of media composition on the vegetative growth of Alternaria brassicicola
PDA media supplemented with different plant extracts showed better vegetative growth. PDA media supplemented with mustard leaf extract showed significantly highest vegetative growth (7.8 cm) of the fungus, followed by supplementation with tomato fruit (7.1 cm) and cabbage leaf (7.1 cm). PDA media with no supplementation i.e. control showed better vegetative growth of A. brassicicola (7.3 cm) compared to the PDA media supplemented with other plant extracts. The PDA media supplemented with carrot fruit, bean fruit and sweet gourd fruit also showed better vegetative growth of A. brassicicola of 7.0 cm, 6.8 cm and 6.4 cm respectively. On the other hand, PDA media supplemented with the combination (treatment No. 8, 9 & 10 in Figure 2) and spinach leaf extract showed poor vegetative growth compared to the other treatments (Figure 3).
 |
Figure 3: Status of vegetative growth of Alternaria brassicicola on PDA media and PDA supplemented with different plant extracts. Click here to View figure |
Influence on spore production of Alternaria brassicicola by the media composition
The data revealed that PDA media supplemented with combination of mustard leaf, tomato fruit, carrot fruit and cabbage leaf extract showed the highest sporulation (11×105spores/ml) of A. brassicicola followed by PDA media supplemented with combination of mustard leaf and tomato extract (925×103spores/ml) and combination of mustard leaf, tomato, carrot (875×103spores/ml) (Table 3). This result indicating that PDA media supplemented with more than one plant extracts produced more spores compared to the PDA media supplemented with one plant extract.
Table 3: Spore production of Alternaria brassicicola by the media composition
|
Treatments |
Spores per ml |
| T0 (Potato dextrose agar) |
33×102 |
| T1 (PDA + Mustard leaf extract) |
64×104 |
| T2 (PDA + Tomato fruit extract) |
55×104 |
| T3 (PDA + Cabbage leaf extract) |
44×104 |
| T4 (PDA + Bean fruit extract) |
25×103 |
| T5 (PDA + Spinach leaf extract) |
75×103 |
| T6 (PDA + Carrot fruit extract) |
225×103 |
| T7 (PDA + Sweet gourd fruit extract) |
9×104 |
| T8 (PDA + Mustard leaf, tomato fruit extract) |
925×103 |
| T9(PDA + Mustard leaf, tomato fruit, carrot fruit extract) |
875×103 |
| T10 (PDA + Mustard leaf tomato carrot cabbage extract) |
11×105 |
Growth characteristics of Bipolaris sorokiniana on PDA media supplemented
with different plant extracts
The colony color of B. sorokiniana having dark brown centre and white margin in case of PDA media and PDA media supplemented with carrot and tomato extract whereas, PDA media supplemented with mustard, bean, cabbage, spinach and sweet gourd showed light brown at center and white at margin, whitish colony with greenish center, whitish colony, cottony white and dark brown colony of B. sorokiniana respectively (Table 4; Figure 4). On the other hand, PDA media supplemented with wheat and rice leaf extract had brownish and dark brown center and greenish at margin of the colony of B. sorokiniana. This result indicating that PDA media supplemented with different plant extracts have an impact on the colony colour of B. sorokiniana. On the other hand, margin of the pure colony of B. sorokiniana on PDA media and PDA supplemented with different plant extracts showed mostly irregular form (Table 4; Figure 4). However, colony on potato mustard leaf agar and potato bean agar was regular.
Table 4: Colony characters of Bipolaris sorokiniana on PDA media supplemented with different plant extracts.
|
Treatments |
Colony characters |
||
|
Substrate color/ media color |
Colony color |
Margin of colony |
|
| T0= Potato dextrose agar |
Light brownish |
Dark brown to whitish at margin | Irregular, wavy margin |
| T1= Potato wheat leaf agar |
Brown |
Brownish | Irregular |
| T2= Potato rice leaf agar |
Brown |
Dark brown at center and greenish at margin | Irregular |
| T3= Potato mustard leaf agar |
Green |
Light brown at center and white at margin | Regular |
| T4= Potato tomato fruit agar |
Reddish |
Dark brown at center and white at margin | Irregular, smooth wavy margin. |
| T5= Potato cabbage leaf agar |
Light green |
Whitish colony | Irregular |
| T6= Potato bean fruit agar |
Light green
|
Whitish colony with greenish center | Thin flat, regular |
| T7= Potato spinach leaf agar |
Dark green |
Cottony White | Thin flat, irregular |
| T8= Potato carrot fruit agar |
Red
|
Dark brown at center and white at margin | smooth irregular |
| T9= Potato sweet gourd fruitagar |
Brown |
Dark brown | Irregular, Wavy margin |
|
Figure 4: Colony colour and appearance of pure colonies of Bipolaris sorokiniana on PDA media supplemented with different plant extracts. Click here to View figure |
Effect of media composition on the vegetative growth of Bipolaris sorokiniana
The result explained that the PDA media supplemented with non-host extracts showed better vegetative growth compared to the host extracts and control. PDA media supplemented with mustard leaf extract showed significantly highest vegetative growth (7.4 cm) of the fungus, followed by PDA media supplemented with spinach leaf extract (7.3 cm) and bean (6.8 cm). The PDA media supplemented with host extracts such as wheat and rice showed less vegetative growth compared to the PDA media supplemented with non-host extracts. Non-host extract PDA media such as potato tomato agar medium, potato sweet gourd agar medium and potato carrot agar medium showed vegetative growth of 4.9 cm, 4.3 cm and 2.9 cm respectively. PDA media with no supplementation with host and non-host extract i.e. control showed poor vegetative growth compared to all other treatments (Figure 5).
 |
Figure 5: Status of vegetative growth of Bipolaris sorokiniana on PDA media and PDA media supplemented with different plant extract. Click here to View figure |
Influence on spore production of Bipolaris sorokiniana by the media composition
To know the effect of media composition on the spore production of B. sorokiniana isolate, 10 different PDA media composition (PDA media supplemented with different host and non-host plant extracts) were used in this research experiment. The data revealed that PDA media supplemented with wheat leaf extract showed the highest sporulation (45×104spores/ml) of B. sorokiniana followed by PDA media supplemented with rice leaf extract (30×105 spores/ml) and PDA media supplemented with sweet gourd extract (1×105ml spores/ml) (Table 5). This result indicated that PDA media supplemented with host extracts produced more spores compared to the PDA media supplemented with non-host extract.
Table 5: Spore production of Bipolaris sorokiniana by the media composition
|
Treatments |
Spore per ml |
| T0 (Potato dextrose agar) |
5×104 |
| T1 (PDA + Wheat leaf extract) |
45×104 |
| T2 (PDA + Rice leaf extract) |
3×105 |
| T3 (PDA + Mustard leaf extract) |
0 |
| T4 (PDA + Tomato fruit extract) |
0 |
| T5 (PDA + Cabbage leaf extract) |
4×104 |
| T6 (PDA + Bean fruit extract) |
0 |
| T7 (PDA + Spinach leaf extract) |
1×104 |
| T8 (PDA + Carrot fruit extract) |
16×103 |
| T9(PDA + Sweet gourd fruit extract) |
1×105 |
Discussion
The experiments were conducted for the evaluation of media composition for growth characteristics of Alternaria brassicicola and Bipolaris sorokiniana, causing black leaf spot of mustard-rapeseed and leaf spot of wheat, respectively. Since the available literature on the present investigations “effect of media composition on the vegetative and reproductive growth of A. brassicicola and B. sorokiniana” is scanty, the available information pertaining to the aspects under study discussed thoroughly in the light of the some literature. In this chapter probable causes of the findings are also discussed in the aspects of the results of previous research findings.
Pathogen culture in the best suitable media is the first step of phytopathological research. For the growth study of A. brassicicola and B. sorokiniana, most of the earlier researchers used the PDA and Potato Dextrose Broth (PDB) media. Some researchers also used the Richard’s broth, Czapek’s dox broth, host extract agar and Sabouraud’s agar medium. But the influence and comparisons among different culture media or PDA media supplemented with different host and non-host plant extracts on the vegetative and reproductive growth of A. brassicicola and B. sorokiniana are the objective of the present research work.
Studies on the growth of A. brassicicola on different PDA media i.e. PDA media supplemented with different plant extracts showed that PDA media supplemented with mustard leaf extract showed significantly highest vegetative growth and PDA with the combination of mustard leaf, tomato fruit, carrot fruit, and cabbage leaf extracts showed highest sporulation. However the fungus was found to grow on all the supplemented culture media tested, but PDA supplemented with mustard leaf extract was more favorable for vegetative growth of A. brassicicola. The present findings is in the conformity with the earlier work by Koley and Mohapatra; Saha et al.11,20 It is concluded that PDA with mustard leaf extract has the simple formulation and mustard leaf has the sufficient nutrient content, suitable for best mycelial growth of the fungus. Chand and Chandra3 recorded maximum vegetative growth of A. brassicicola on host extract media. Mohapatra et al. 15 stated that maximum growth of Alternaria sesame (infecting sesame) on PDB compared to Richard’s, Czapek’s dox and oat meal broth media. In addition, Somappa et al. 24 reported that PDB is the best medium supporting good growth of A. solani infecting tomato. These results indicated that complex formulation of the media does not allow the fast mycelial growth of A. brassicicola.
On the other hand, PDA media with the combinations of plant extracts (mustard leaf, tomato fruit, carrot fruit and cabbage leaf) showed the highest sporulation and lowest sporulation observed in PDA media without supplementation with plant extracts. This result indicated that the complex formulation of PDA medium with host extracts allow the fast sporulation of A. brassicicola. It might be due to PDA media with mustard leaf, tomato fruit, carrot fruit and cabbage leaf extracts contain all the major compounds for fungal sporulation i.e. carbon, nitrogen, phosphate, potassium, magnesium, sulphur elements including sugars. This finding also corroborates the findings of earlier researchers. Osman et al.18 found Czapek’s Dox Agar medium was best for the growth and sporulation of Alternaria alternata. Fancelli and Kimati7 also observed that Czapek’s Dox and host leaf extract medium yielded better sporulation of Alternaria dauc icompared to other tested media. Singh20 found that the fungus grew well on various natural media but oat meal agar proved best and excellent sporulation was detected in potato dextrose agar. Waggoner and Horsfall29 reported that A. solani requires a carbon source (sugar) for higher sporulation, but high availability of sugar inhibits the conidia production.
In case of Bipolaris sorokiniana, PDA with mustard leaf showed significantly highest vegetative growth and lowest vegetative growth was found in PDA media without supplementation with plant extract. These results indicated that PDA media supplemented with plant extracts enhanced vegetative growth of B. sorokiniana. It might be due to PDA supplementation with plant extracts has the sufficient nutrient content, supporting the best mycelial growth of the fungus. On the other hand, PDA media supplemented with wheat leaf extract showed the highest sporulation followed by PDA media supplemented with rice leaf extract. These findings are indicating that Bipolaris fungus showed better sporulation on PDA media supplemented with graminaceous plant extracts compared to other plant extracts. These results corroborate the findings of former literatures such as Chattopadhyay and Dasgupta4 found that production of conidia by B. oryzae was favored by media either rich in or made exclusively of plant parts. Coleman et al.5 showed that methionine and ethylene both reduced mycelium growth of B. sorokiniana when grown on Czapek’s medium or on media containing grass leaf infusion. Methionine and other amino acids reduced sporulation as did ethylene and precursors of ethylene, S-adenosylmethionine and 1-aminocyclopropane-1- carboxylic acid. Cegielko2 examined that faster growth of Drechslera avenae recorded in MPA (maltose peptone agar) medium and RA (rye agar) were the best media for the sporulation of D. avanae. Garraway and Evans8 observed xylose (1.0-10.0 g/L) stimulates sporulation but not mycelial growth of B. maydis when added as a supplement to a basal agar medium containing glucose, sporulation on a xylose-supplemented medium was significantly higher than on a non-supplemented control medium. Sharma and Singh21 found that rice husk agar and near ultraviolet radiation were required for production of conidia by Helminthosporium oryzae.
Conclusion
In the present investigation, maximum mycelial growth of both A. brassicocola and B. sorokiniana were obtained in PDA supplemented with mustard leaf while maximum sporulation of A. brassicocola and B. sorokiniana found in PDA supplemented with all plant extracts combination and PDA supplemented with wheat leaf respectively. Based on these findings it may be concluded that PDA supplementation with extract of single or combination of host plant extracts, the sporulation of the two fungi can be enhanced.
Acknowledgements
The study was supported partly by the Bangladesh Agricultural University Research System (BAURES), Bangladesh Agricultural University, Mymensingh, Bangladesh. We also thank the Department of Plant Pathology and Seed Pathology Center, Bangladesh Agricultural University for providing research facilities.
References
-
- Barnett, H. G. 1967. Illustrated genera of imperfect fungi. Burgess Publ. Co. Minneapolis, USA. 223.
- Cegiełko, M. Effects of culture conditions on the growth and morphology of 20 strains of Drechslera avenae (Eidam) Scharif. ActaAgrobotanica. 2010;63(1):149–160.
CrossRef - Chand, G. Chandra, K. K. Symptomological, cultural and molecular variability of Alternaria brassicicola leaf spot in broccoli (Brassica oleracea var. Italica L.). Int. J. Pharm. Bio. Sci. 2014;5(2):680-688.
- Chattopadhya,S. B., Dasgupta D. Factors affecting conidial production Helminthosporiumoryzae. Indian Phytopathol. 1965;18:60-167.
- Coleman, L. W., Clinton F. Hodge. Growth and sporulation of Bipolaris sorokiniana in response to methionine and ethylene. Science Direct. 1990;94(8):1013-101.
CrossRef - Ellis, M. B. Dematiaceou shyphomycetes. Commonwealth Agril. Bureau. 1971;608.
- Fancelli, M. I. Kimati, H. Influence of culture media and florescent light on the sporulation of Alternaria dauci.R.P.P. 1991;70(10):806.
- Garraway, M. O., Evans, R. C. Sporulation in Bipolaris maydis: enhancement by xylose. Phytopathol. 1977;67:990-993.
CrossRef - ISTA. International rules for Seed Testing. Seed Science and Technology. 1996;4:3-49.
- Kirk, P. M., Cannon, P. F, Minter, D. W and Stalpers, J. A. Dictionary of the fungi. 10thed. Wallingford: CABI. 22. 2008.
- Koley, S. Mohapatra, S. S. Evaluation of culture media for growth characteristics of Alternaria solani, causing early blight of tomato. J. Plant Pathol. Microbiol. 2015;3:1.
- Kumara, K. L. W., Rawal, R. D. Influence of carbon, nitrogen, temperature and pH on the growth and sporulation of some Indian isolates of Colletotrichum gloeosporioides causing anthracnose disease of papaya (Carrica papaya L). Trop. Agric. Res. Ext. 2008;11:7- 12.
CrossRef - Kuhn, D. M. and Ghannoum, M. A. Indoor mold, toxigenic fungi, and Stachybotrys chartarum: infectious disease perspective. Clinic Microbiology Reviews. 2003;16(1):144-172.
CrossRef - Madigan, M., Martinko, J. Brock Biology of micro-organism (11th ed.). Prentice Hall. 2005.
- Mohapatra, A., Mohanty, A. K., Mohanty, N. N., 1977. Studies on the physiology of the sesamum leaf light pathogen, Alternaria sesame. Indian Phytopathol. 30(3):432-434.
- Northolt, M. D., Bullerman, L. B. Prevention of mold growth and toxin production through control of environmental condition. J. Food Prot. 1982;6:519-526.
CrossRef - Nowicki and Marcin. Alternaria black spot of crucifers: Symptoms, importance of diseases, and perspectives of resistance breeding. Vegetable crop Research Bulletin. 2012;76.
- Osman, M., El-sayed, Mohamed, M. A., YAH, Metwally, M. Effect of various culture conditions on Alternaria alternate and Fusariumoxysporum. R.P.P. 1993;72(8):581.
- Robert, A. Shoemaker. Bipolaris. English Wikipedia – Species Pages. Wikimedia Foundation. 1959.
- Saha, A., Mandal, P., Dasgupta, S., Saha, D. Influence of culture media and environmental factors on mycelial growth and sporulation of Lasiodiplodiatheobromae (Pat.) Griffon and Maubl.J. Environ. Biol. 2008;29:407-410.
- Sharma, V. V., Singh, R. A. Influence of light and media on the sporulation of Helminthosporium oryzae. Indian phytopathol. 1975;28:83-85.
- Singh, D. B. Effect of culture media, pH, and temperature on growth behavior of Alternaria brassicae and Drechslera graminea. Proc. Indian Natn. Sci. Acad. 1980;46(3):393-396.
- Sivanesan, A. Graminicolous species of Bipolaris, Curvularia, Drechslera, Exerohilum, and their teleomorphs. Mycol. Pap. 1987;158: 1-261.
- Somappa, J., Srivastava, K., Sarma, B. K., Pal Cand Kumar, R. Studies on growth conditions of the tomato Alternaria leaf spot causing AlternariaSolani. The bioscan. 2013;8(1):101-104.
- St-Germain, G., Summerbell, R. Identifying filamentous, Fungi- A clinical Laboratory Handbook. 1st Ed. Star Publishing Co. Belmont. California. 1996.
- Tewari, J. D., Buchwaldt. Disease caused by fungi and oomycetes. In Rimmer S.R.; Shattack V.; Buchwald L., (eds). Compendium of Brassica diseases st. Paul: ADS press. 2007;15-18.
- Toratora, G. J., Funk, B. R., Case, C. L. Microbiology an introduction, 5th Ed. The Benjamin/Cummings, New York. 1995;147-150.
- Tuite, J. Plant Pathological methods: Fungi and Bacteria. Dept. of Botany and Plant Pathology, Purdue University, Lafayette, Ludhiana. 1969;239.
- Waggoner, P. E., Horsfall, J. G. EPIDEM. A simulator of plant disease written for a computer. Bulletin of the Connecticut Agricultural Experiment Station, New Haven. 1969;698: 1-80

